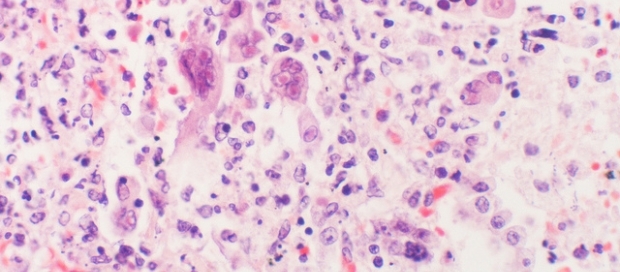

. (CC BY-SA 2.0)
American researchers think they have discovered a new treatment for the herpes virus, an infection affecting about 90% of the adult population.
The herpes simplex virus is linked to recurrent cold sores and genital ulcers. Once an individual is infected it typically establishes a latent infection in the body, periodically flaring up and staying within the nervous system for life.
Common triggers for these flare-ups include stress, skin injury, sunburn, or menstruation. Although there are drugs that can control the active infection, including the well-known agent aciclovir, they are powerless to prevent these reactivations.
Now a team of scientists based at Louisiana State University has found a way to tweak the DNA structure of the hiding virus, sending it to sleep so it cannot reactivate so readily.
They gave herpes-infected mice, rabbits and guinea pigs doses of an anti-depressant drug called tranylcipromine. This blocks an enzyme in cells known as LSD-1 (lysine-specific demethylase-1), making the virus harder to activate.
"This looks like a promising new avenue that has been dubbed an epipharmaceutical because it works epigenetically against the virus to stop it coming back.' But he says some caution is required; "...the doses required to achieve the suppressive effects on herpes viruses were much higher than those used for treating depression, suggesting that side effects might be an issue. For this reason, scientists are developing compounds capable of targeting the LSD-1 enzyme specifically."